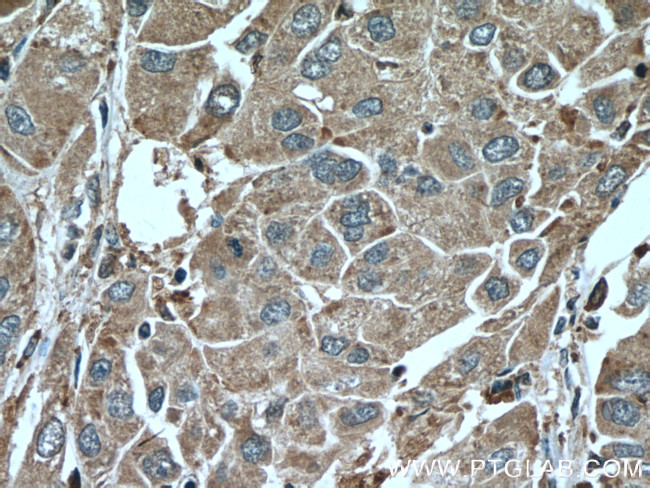
SERPINA7 Antibody in Immunohistochemistry (Paraffin) (IHC (P))

Search
Proteintech
SERPINA7 Monoclonal Antibody (1B11B10)
{{$productOrderCtrl.translations['antibody.pdp.commerceCard.promotion.promotions']}}
{{$productOrderCtrl.translations['antibody.pdp.commerceCard.promotion.viewpromo']}}
{{$productOrderCtrl.translations['antibody.pdp.commerceCard.promotion.promocode']}}: {{promo.promoCode}} {{promo.promoTitle}} {{promo.promoDescription}}. {{$productOrderCtrl.translations['antibody.pdp.commerceCard.promotion.learnmore']}}
产品信息
66454-1-IG
种属反应
宿主/亚型
分类
类型
克隆号
抗原
偶联物
形式
浓度
规格
纯化类型
保存液
内含物
保存条件
运输条件
产品详细信息
Immunogen sequence: TLYKMSSIN ADFAFNLYRR FTVETPDKNI FFSPVSISAA LVMLSFGACC STQTEIVETL GFNLTDTPMV EIQHGFQHLI CSLNFPKKEL ELQIGNALFI GKHLKPLAKF LNDVKTLYET EVFSTDFSNI SAAKQEINSH VEMQTKGKVV GLIQDLKPNT IMVLVNYIHF KAQWANPFDP SKTEDSSSFL IDKTTTVQVP MMHQMEQYYH LVDMELNCTV LQMDYSKNAL ALFVLPKEGQ MESVEAAMSS KTLKKWNRLL QKGWVDLFVP KFSISATYDL GATLLKMGIQ HAYSENADFS GLTEDNGLKL SNAAHKAVLH IGEKGTEAAA VPEVELSDQP ENTFLHPIIQ IDRSFMLLIL ERSTRSILFL GKVVNPTEA (38-415 aa encoded by BC020747)
靶标信息
There are three proteins including thyroxine-binding globulin (TBG), transthyretin and albumin responsible for carrying the thyroid hormones thyroxine (T4) and 3,5,3'-triiodothyronine (T3) in the bloodstream. This gene encodes the major thyroid hormone transport protein, TBG, in serum. It belongs to the serpin family in genomics, but the protein has no inhibitory function like many other members of the serpin family. Mutations in this gene result in TGB deficiency, which has been classified as partial deficiency, complete deficiency, and excess, based on the level of serum TBG. Alternatively spliced transcript variants encoding different isoforms have been found, but the full-length nature of these variants has not been determined.
仅用于科研。不用于诊断过程。未经明确授权不得转售。
篇参考文献 (0)
生物信息学
蛋白别名: mutant serpin family A member 7; RP1-82J11.2; serine (or cysteine) peptidase inhibitor, clade A (alpha-1 antipeptidase, antitrypsin), member 7; serine (or cysteine) peptidase inhibitor, clade A (alpha-1 antiproteinase, antitrypsin), member 7; serine (or cysteine) proteinase inhibitor clade A (alpha-1 antiproteinase antitrypsin) member 7; serine (or cysteine) proteinase inhibitor, clade A (alpha-1 antiproteinase, antitrypsin), member 7; Serpin A7; serpin peptidase inhibitor, clade A (alpha-1 antiproteinase, antitrypsin), member 7; serum thyroxine-binding protein; T4-binding globulin; TBG Glencoe; mutant TBG causing partial TBG deficiency; thyroxin-binding globulin; thyroxine binding globulin; Thyroxine-binding globulin; thyroxine-binding globulin precursor
基因别名: C730040N12Rik; SERPINA7; TBG; TBGQTL
UniProt ID: (Human) P05543, (Pig) Q9TT35, (Mouse) P61939
Entrez Gene ID: (Human) 6906, (Pig) 397125, (Rat) 81806, (Mouse) 331535